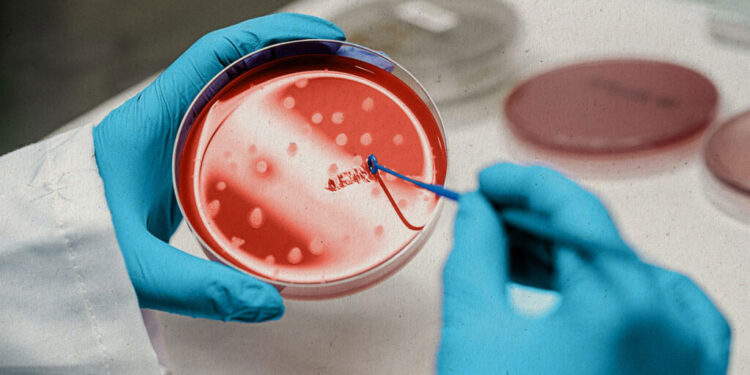
‘स्टेम सेल’ थेरापीबाट एचआईभी संक्रमित महिलाको सफल उपचार

एजेन्सी ।
संयुक्त राज्य अमेरिकामा पहिलो पटक ‘स्टेम सेल’ थेरापीबाट एचआईभी संक्रमित एक महिलाको सफल उपचार भएको छ । ‘स्टेम–सेल’ थेरापीपछि एचआईभी जितेकी ती महिला ल्यूकेमिया (रक्त क्यान्सर) को बिरामीसमेत रहेको बताइएको छ ।
निकै जोमिमपूर्ण उपचार मानिने यस विधिबाट न्यूयोर्कस्थित प्रेस्बिटेरियन वेल कर्नल मेडिकल सेन्टरमा ती महिलाको सफल उपचार भएको हो । उनी एचआईभीमुक्त हुने पहिलो महिला एवम् चौथो व्यक्ति हुन् ।
यसअघि एचआईभी संक्रमित तीनजना पुरुषको सफल उपचार भइसकेको छ । ती महिलालाई २०१३ मा एचआईभी र २०१७ मा ल्यूकेमिया भएको थियो । चार वर्षसम्म उपचार गरेपछि उनी क्यान्सरमुक्त भएकी थिइन् ।
सफल उपचारपछि वैज्ञानिकहरूले एन्टिरेट्रोभाइरल थेरापीको आवश्यकताविना धेरै मानिसलाई उपचार उपलब्ध गराउन सक्ने विश्वास लिएका छन् । ‘स्टेम–सेल’ थेरापी क्यान्सर र एचआईभी जस्ता गम्भीर रोगको उपचार वा रोकथाम गर्न अपनाइने एक विधि हो ।

आफ्नो प्रतिक्रिया दिनुहोस् !